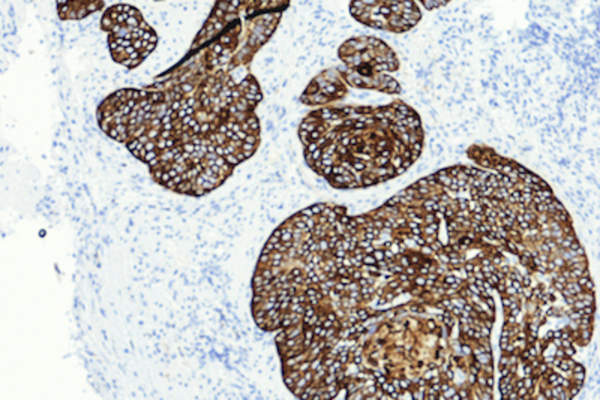
显微镜下的鳞状细胞癌。

了解如何对付膀胱癌的第一步是了解它。熟悉这些关键术语将帮助你更好地了解你的疾病和医生的治疗方法。反过来,你也可以更好更自信地驾驭自己的膀胱癌之旅。

你的膀胱在哪里?它有什么作用?
膀胱是一个气球形状的器官,位于胸部和骨盆之间。你的身体利用膀胱储存尿液,直到你排尿排空。膀胱由三组肌肉组成,它们共同工作,在你排尿前将尿液留在膀胱内:尿道、内括约肌和外括约肌。当你排尿时,你的大脑会向膀胱壁发送信号将尿液挤出,并向外括约肌发送信号通过尿道释放尿液。

侵入性和非侵入性的
非侵袭性膀胱癌只存在于移行上皮(膀胱的内层),并没有扩散到膀胱的深层。侵袭性膀胱癌已经生长到膀胱壁的各个层,更容易扩散,而且很难治疗。
尿路上皮癌和鳞状细胞癌

腺癌
腺癌是膀胱癌的另一种形式,在美国很少见。它开始于排列在膀胱上的腺体形成细胞,并向膀胱内释放粘液。大多数膀胱腺癌是侵袭性的。

暂存
膀胱癌分期是医生用来确定膀胱癌的侵袭程度和扩散范围的一种方法。它是决定如何治疗膀胱癌的最重要的技术之一。阶段范围从0到4,还可以包括提供更多信息的字母。较低的数字意味着癌症处于早期阶段,而较高的数字意味着癌症处于晚期。

膀胱免疫治疗和免疫检查点抑制剂
膀胱免疫疗法和免疫检查点抑制剂迫使身体攻击自己的癌细胞。在膀胱免疫治疗过程中,通过导管将活菌放入膀胱内。当身体攻击膀胱中的细菌时,它也杀死了膀胱癌细胞。注射免疫检查点抑制剂帮助免疫系统区分健康细胞和有害细胞,然后攻击有害细胞。

全身化疗和膀胱化疗
化疗是一种杀死癌细胞的药物。在全身化疗在美国,人们要么以药丸的形式接受化疗,要么将化疗注射到静脉或肌肉中。这使得化疗可以到达身体其他部位的癌细胞以及膀胱。在膀胱内化疗期间,医生将液体化疗药物直接插入膀胱内,杀死仅在膀胱内层的癌细胞。

经尿道膀胱切除术
经尿道膀胱切除术(TURBT)是一种确定某人是否患有膀胱癌以及膀胱癌是否已扩散到膀胱壁肌肉的外科手术。它也用于治疗早期膀胱癌。TURBT是一种无创手术。外科医生将一根末端装有摄像机、光源和线圈的细管插入尿道,用它来切除癌肿瘤和组织,然后将其送往实验室进行检测。

Cysectomy
膀胱切除术包括外科医生切除部分膀胱(部分膀胱切除术)或全部膀胱(根治性膀胱切除术)。接受这种手术的男性也会切除前列腺和精囊,而女性也会切除输卵管、子宫、子宫颈和部分阴道。接受根治性膀胱切除术的人还必须进行再造手术,以使他们的身体有另一种方式储存和释放尿液。